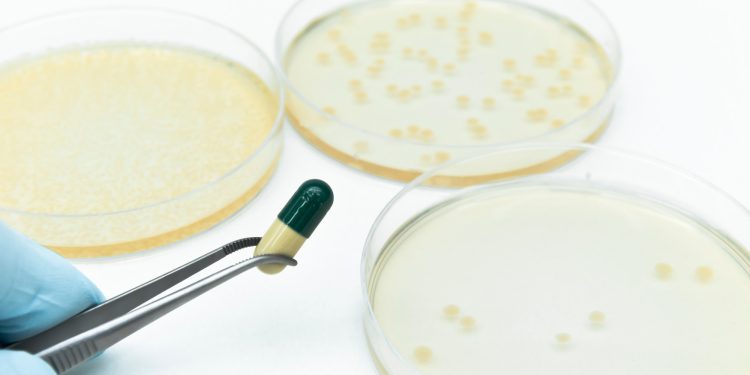

Health
Racing against antibiotic resistance
Scientists fear funding cuts will slow momentum in ongoing battle with evolving bacteria
A series exploring how research is rising to major challenges in health and society
In 2023, more than 2.4 million cases of syphilis, gonorrhea, and chlamydia were diagnosed in the U.S. Though that number is high, it’s actually an improvement, according to the Centers for Disease Control and Prevention: The number of sexually transmitted infections, or STIs, decreased 1.8 percent overall from 2022 to 2023, with gonorrhea decreasing the most (7.2 percent).
But the number of STI diagnoses is only one part of the problem.
One treatment for STIs is doxycycline. It has been prescribed as a prophylactic for gonorrhea, recommended as a treatment for chlamydia since 2020, and used to treat syphilis during shortages of the preferred treatment, benzathine penicillin. But bacteria are living organisms, and like all living organisms, they evolve. Over time, they develop resistance mechanisms to the antibiotics we create to kill them. And according to Harvard immunologist Yonatan Grad, resistance to doxycycline is growing rapidly in the bacteria that cause gonorrhea.
“The increased use of doxycycline has, as we might have expected, selected for drug resistance,” Grad said.
The pattern of bacteria evolving to overcome our best treatments is one of medicine’s most fundamental problems. Since the introduction of penicillin in the 1940s, antibiotics have radically transformed what’s possible in medicine, far beyond treatments for STIs. They can knock out the bacteria behind everything from urinary tract infections to meningitis to sepsis from infected wounds. But every antibiotic faces the same fate: As soon as it enters use, bacteria begin evolving to survive it.
The scope of the problem is staggering. Doctors wrote 252 million antibiotic prescriptions in 2023 in the U.S. That’s 756 prescriptions for every 1,000 people, up from 613 per 1,000 people in 2020. According to the CDC, more than 2.8 million antimicrobial infections occur each year in the U.S., and more than 35,000 people die, as a result of antimicrobial-resistant (AMR) infections.
“I think of antibiotics as infrastructure.”
Yonatan Grad
For researchers like Grad, the endless battle against the clock can be a bit like a game of high-stakes Whac-a-Mole — tracking antibiotic resistance, figuring out how it works, and developing new kinds of drugs before the bacteria can catch up.
“Being able to treat these infections underlies so many aspects of medicine — urinary tract infections, caring for people who are immunocompromised, preventing surgical infections and treating them if they arise, and on and on,” said Grad. “This is foundational for modern clinical medicine and public health. Antibiotics are the support, the scaffolding on which medicine depends.”
Hold or release new drugs?
Grad’s research shows how quickly resistance can develop. In research described in a July letter in the New England Journal of Medicine, Grad and colleagues evaluated more than 14,000 genome sequences from Neisseria gonorrhoeae, the bacteria that causes gonorrhea, and found that carriage of a gene that confers resistance to tetracyclines — the class of antibiotics to which doxycycline belongs — shot up from 10 percent in 2020 to more than 30 percent in 2024.
Fortunately, doxycycline remains effective as a post-exposure prophylaxis for syphilis and chlamydia. It’s an open question why some pathogens are quicker to develop resistance than others. The urgency varies by organism, Grad said, with some, like Mycobacterium tuberculosis, the cause of tuberculosis, and Pseudomonas aeruginosa, showing “extremely drug-resistant or totally drug-resistant strains” that leave doctors facing untreatable infections.
The findings raise alarm bells, or at least questions, in doctors’ offices around the country: As bacteria develop resistance to tried-and-true antibiotics, when should new drugs be introduced for maximal utility before the bacteria inevitably outwit them, too? Traditional stewardship practice has recommended holding back new drugs until the old ones stop working. But 2023 research from Grad’s lab has challenged that approach. In mathematical models evaluating strategies for introducing a new antibiotic for gonorrhea, Grad found that the strategy of keeping the new antibiotics in reserve saw antibiotic resistance reach 5 percent much sooner than quickly introducing the antibiotic or using it in combination with the existing drug.
Lifesaving progress halted
Extra time could be critical for Amory Houghton Professor of Chemistry Andrew Myers, whose lab has been developing new antibiotics, including ones that target gonorrhea, for more than 30 years.
“Most of the antibiotics in our ‘modern’ arsenal are some 50 years old and no longer work against a lot of the pathogens that are emerging in hospitals and even in the community,” Myers said. “It’s a huge problem and it’s not as well appreciated as I think it should be.”
“In my opinion, we can absolutely win the game — temporarily.”
Andrew Myers
Many antibiotics work by targeting and inhibiting bacterial ribosome, the central machinery that translates the instructions in RNA into a protein readout. Ribosomes are “fantastically complex” 3D shapes, Myers said. Creating new antibiotics means inventing new chemical compounds that can bind like puzzle pieces into their grooves and protrusions.
“My lab will spend quite a lot of time, sometimes years, to develop the chemistry — to invent the chemistry — that allows us to prepare new members of these classes of antibiotics,” Myers said. “And then we spend years making quite literally thousands of different members of the class, and then we evaluate them. Do they kill bacteria? Do they kill bacteria that are resistant to existing antibiotics? We’ve been incredibly successful with this, one antibiotic class after another. The strategy works.”
But it’s also in danger. The Trump administration ended a National Institutes of Health grant to Myers’ lab for the development of lincosamides, a class of antibiotics whose last approved member, clindamycin, dates to 1970. A second terminated NIH grant may kill a promising new antibiotic on the cusp of further development. Myers’ lab has created a new molecule that has proven effective in killing Klebsiella Pneumoniae and E. coli, both identified by the World Health Organization as among the highest priority pathogens. Without continued funding, the molecule may not make it to the clinical trial phase and may never become an approved drug.
“A delusion among people is that these decisions can simply be reversed and these NIH grants restored,” Myers said. “That’s not true. The damage is real, and it’s irreversible in some cases.”
Carrying on Paul Farmer’s legacy
The funding cuts extend beyond individual labs to a global health infrastructure. Carole Mitnick, a professor of global health and social medicine at Harvard Medical School, studies multidrug-resistant tuberculosis (MDR-TB) and has watched about 79 percent of USAID funding for global TB support get slashed this year.
“In the Democratic Republic of Congo, in Sierra Leone, and no doubt elsewhere, we’ve seen stocks of lifesaving anti-TB drugs sitting in warehouses, expiring, because programs that would have delivered them have been canceled or staff who would have collected them have been abruptly fired,” she said. “Not only is it immediately deadly and cruel not to deliver these lifesaving cures, but it sets the scene for more antimicrobial resistance by not delivering complete treatments. And it very clearly wastes U.S. taxpayer money to invest in the purchase of these drugs and let them sit in warehouses and expire.”
Mitnick’s work on multidrug-resistant TB, a form of antimicrobial resistance, builds on the legacy of Paul Farmer, the late Harvard professor and Partners In Health co-founder who revolutionized MDR-TB treatment by rejecting utilitarian approaches that wrote off the most vulnerable patients.
“Getting to know Paul and having him advise me, initially on my master’s thesis and ultimately on my doctoral dissertation, gave me a new framework,” Mitnick said. “It allowed me the freedom to use a social justice framework and to say that actually our research should be motivated by who’s suffering the greatest. How do we blend the research, which we’re very well placed to do at Harvard, with direct service and trying to reach the populations who are most marginalized? That shape is still very much in place and still informing the choices that several researchers in our department make in Paul’s legacy.”
“Our research should be motivated by who’s suffering the greatest.”
Carole Mitnick
Globally, about 500,000 new people are estimated to have MDR-TB or its even heartier relative, extensively drug-resistant TB, each year. MDR-TB caused an estimated 150,000 deaths worldwide in 2023. TB is the poster child for pathogen characteristics and social conditions that favor selection for drug-resistant mutants. In a single case of TB, the bacteria population comprises bacteria at different stages of growth and in different environments of the body, requiring distinct drugs that can attach to each of these forms. Multidrug treatment regimens are long (measured in months, not days) and toxic, making them difficult for people to complete. And in the absence of any incentives or requirements, there’s a long lag between developing new drugs and developing tests that can detect resistance to those drugs. Consequently, treatment is often delivered without any information about resistance, in turn generating more resistance.
The fight against MDR-TB has an unlikely new ally: Nerdfighters, the fan group of prominent video bloggers John and Hank Green — or, more specifically, a subset of that fandom calling themselves TBFighters. John Green’s 2024 book, “Everything is Tuberculosis,” raised awareness about the prohibitive cost of TB diagnostic tests.
Mitnick said that in the acknowledgments, Green called his book a sort of love letter to Paul Farmer. “Paul didn’t directly introduce John to TB, but it really is Paul’s legacy that took John Green to Sierra Leone, and then he met this young man named Henry who had multidrug-resistant tuberculosis. It awakened in John the awareness that actually TB was not a disease of the past, but a disease very much of the present.”
The TBFighters energized an existing coalition movement to reduce the cost of testing for TB and other diseases from about $10 per test to about $5 per test, based on estimates that $5 covered the cost of manufacturing plus a profit, even at lower sales volumes.
“It wasn’t until John Green and the TBFighters entered the fray in 2023 that we made any headway: The manufacturer announced a reduction of about 20 percent on the price of one TB test,” Mitnick said. “So not a full win, but a partial win.”
Despite the challenges, researchers remain cautiously optimistic. “In my opinion, we can absolutely win the game — temporarily,” said Myers. “Whatever we develop, bacteria will find a way to outwit us. But I’m optimistic that the molecules that we’re making could have a clinical lifetime of many decades, maybe even as long as 100 years, if they’re used prudently.”
Grad sees his work more like the construction crews that repair the city sidewalk or maintain bridges. “I think of antibiotics as infrastructure,” he said. “These tools that we use to maintain our health require continual investment.”